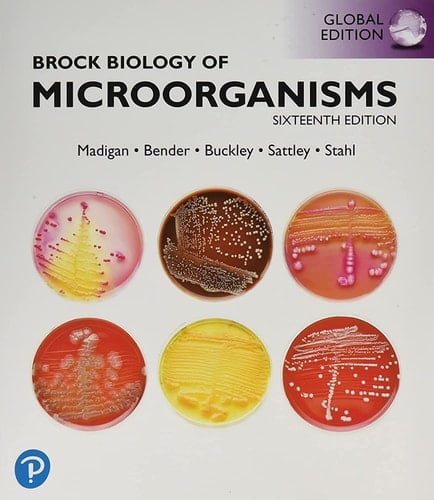
Brock Biology of Microorganisms

Get a solid understanding of the major concepts in microbiology with a textbook that offers cutting-edge research findings, powerful tools, and visuals. Brock Biology of Microorganisms, Global Edition, 16th Edition is the latest version of the most authoritative textbook in the field, offering powerful, accurate, yet accessible content surrounding the basic concepts of microbiology. The text guides you through the six major themes of microbiology -- Evolution, Cell Structure and Function, Metabolic Pathways, Information Flow and Genetics, Microbial Systems, and the Impact of Microorganisms -- as outlined by the American Society for Microbiology Conference on Undergraduate Education (ASMCUE). Following a modern robust approach, the book supports your knowledge of the genomics and other "omics" maze - concepts that are fundamental to the field and have transformed and revolutionised microbiology. Furthermore, it provides concrete examples of how powerful tools have allowed microbiologists to probe deeper and further into the microbial world than ever before. Besides offering an overview of the essential principles surrounding the microbial world that all students need to master, this edition brings the most basic relevant concepts to life by further expanding on art programs, ensuring you experience microbiology as a visual science. With each chapter focusing on a specific scientific theme, the text allows you to connect and engage with the latest, most exciting real-world topics. Check out the preface for a complete list of features and what is new in this edition. Personalise your learning experience and improve results with Mastering® Microbiology. Mastering provides access to trusted content using customisable tools, features, and assessments built for today's digital learners. If you would like to purchase both the physical text and Mastering Biology, search for: 9781292405230 Brock Biology of Microorgani
Page Count:
1128
Publication Date:
2021-05-27
ISBN-10:
1292404795
ISBN-13:
9781292404790
No comments yet. Be the first to share your thoughts!